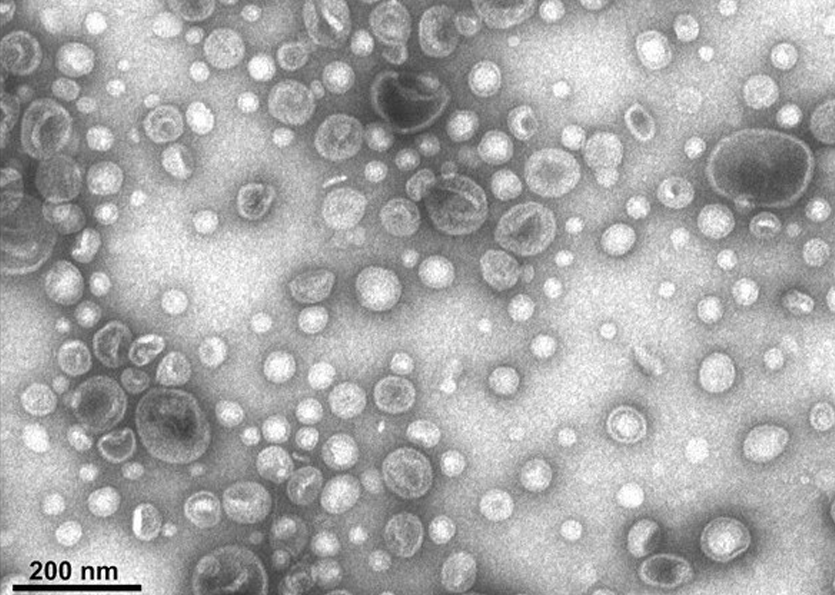
Les bactéries résistantes : plus virulentes et redoutables

Pour la première fois, des chercheurs ont découvert un lien inquiétant entre la résistance aux antibiotiques et l’agressivité accrue des bactéries.
**Un mécanisme complexe**
Cette découverte, publiée dans la revue « Antimicrobial Agents and Chemotherapy », révèle un mécanisme complexe par lequel les bactéries développent des stratégies de résistance qui leur confèrent également des capacités de virulence renforcées. Ce mécanisme implique une réorganisation du génome bactérien qui conduit à l’expression de gènes responsables à la fois de la résistance et de la virulence.
**Des conséquences alarmantes**
« Cette découverte est alarmante car elle suggère que l’utilisation excessive d’antibiotiques pourrait favoriser l’émergence de bactéries non seulement résistantes, mais également plus dangereuses », explique le Dr Pierre-Emmanuel Fournier, co-auteur de l’étude.
**Des données inquiétantes**
Des études récentes ont montré que les bactéries résistantes aux antibiotiques sont responsables d’un nombre croissant d’infections graves, dont certaines sont devenues presque impossibles à traiter. En France, on estime que les bactéries résistantes sont à l’origine de 12 000 décès par an.
**Une menace pour la santé publique**
« Cette découverte souligne l’importance de réduire l’utilisation d’antibiotiques et de développer de nouvelles stratégies pour lutter contre les infections bactériennes », déclare le Pr Philippe Glaser, co-auteur de l’étude. « Il est crucial de continuer les recherches sur les mécanismes de résistance et de virulence pour développer de nouvelles thérapies et prévenir la menace croissante des bactéries résistantes. »
**Conclusions**
La résistance aux antibiotiques est un problème de santé publique majeur qui ne cesse de s’aggraver. La découverte du lien entre la résistance et la virulence est une sonnette d’alarme qui appelle à une action urgente pour lutter contre cette menace et protéger la santé de tous.
**Mots-clés :** Résistance aux antibiotiques, virulence, bactéries, infections, santé publique
